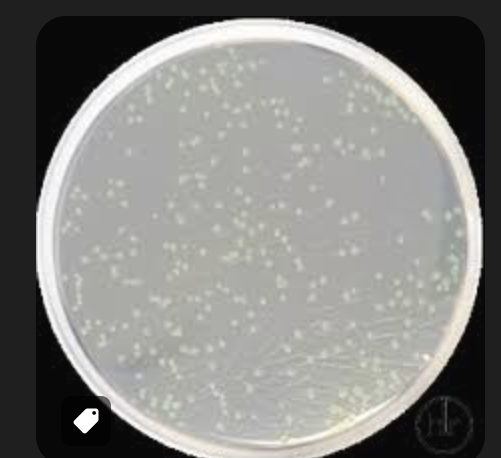
ПОЖИВНИЙ АГАР / NUTRIENT AGAR САНІМЕД-М

24930000-2 Фотохімікати
Назва категорії: Живильні середовищаОдиниці виміру: штука
Технічні характеристики
Вид
Відповідність ДСТУ EN ISO 11133:2014
Фасування
Основа складу
Знайдено: 253

Емульсія яєчного жовтка з телуритом / EGG YOLK TELLURITE EMULSION, Sanimed-M

Основа уреазного агару за Крістенсеном / CHRISTENSEN UREA AGAR BASE, Sanimed-M

Флакони для анаеробного культивування крові (дорослі), з адсорбентом, LITUO

Лактозо-цистеїнове середовище з бромтимоловим синім (C.L.E.D.), Sanimed-M
ПОЖИВНИЙ АГАР / NUTRIENT AGAR САНІМЕД-М

Агар Сабуро з глюкозою та хлорамфеніколом 500 мг

Агар Сабуро з глюкозою та хлорамфеніколом 50 мкг

Агар Мюллера-Хінтона з 5% кінською кров`ю і 20 мг/л β-НАД / MUELLER HINTON AGAR with 5% HORSE BLOOD and 20 mg/l β-NAD, Sanimed-M

Агар МакКонкі з кристалвіолетом і 0,15% жовчних солей /MACCONKEY AGAR w/ CV, NaCl AND 0,15% BILE SALTS, Sanimed-M

Агар Оксфорда, основа

Сольовий агар з манітом/MANNITOL SALT AGAR, Sanimed -M
